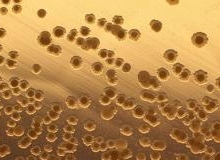

Выполнены новые этапы разработки российского толерантного топлива для АЭС
В исследовательском реакторе МИР в АО «ГНЦ НИИАР» завершился второй цикл облучения тепловыделяющих сборок с экспериментальными твэлами для реакторов ВВЭР и PWR в «толерантном» исполнении.